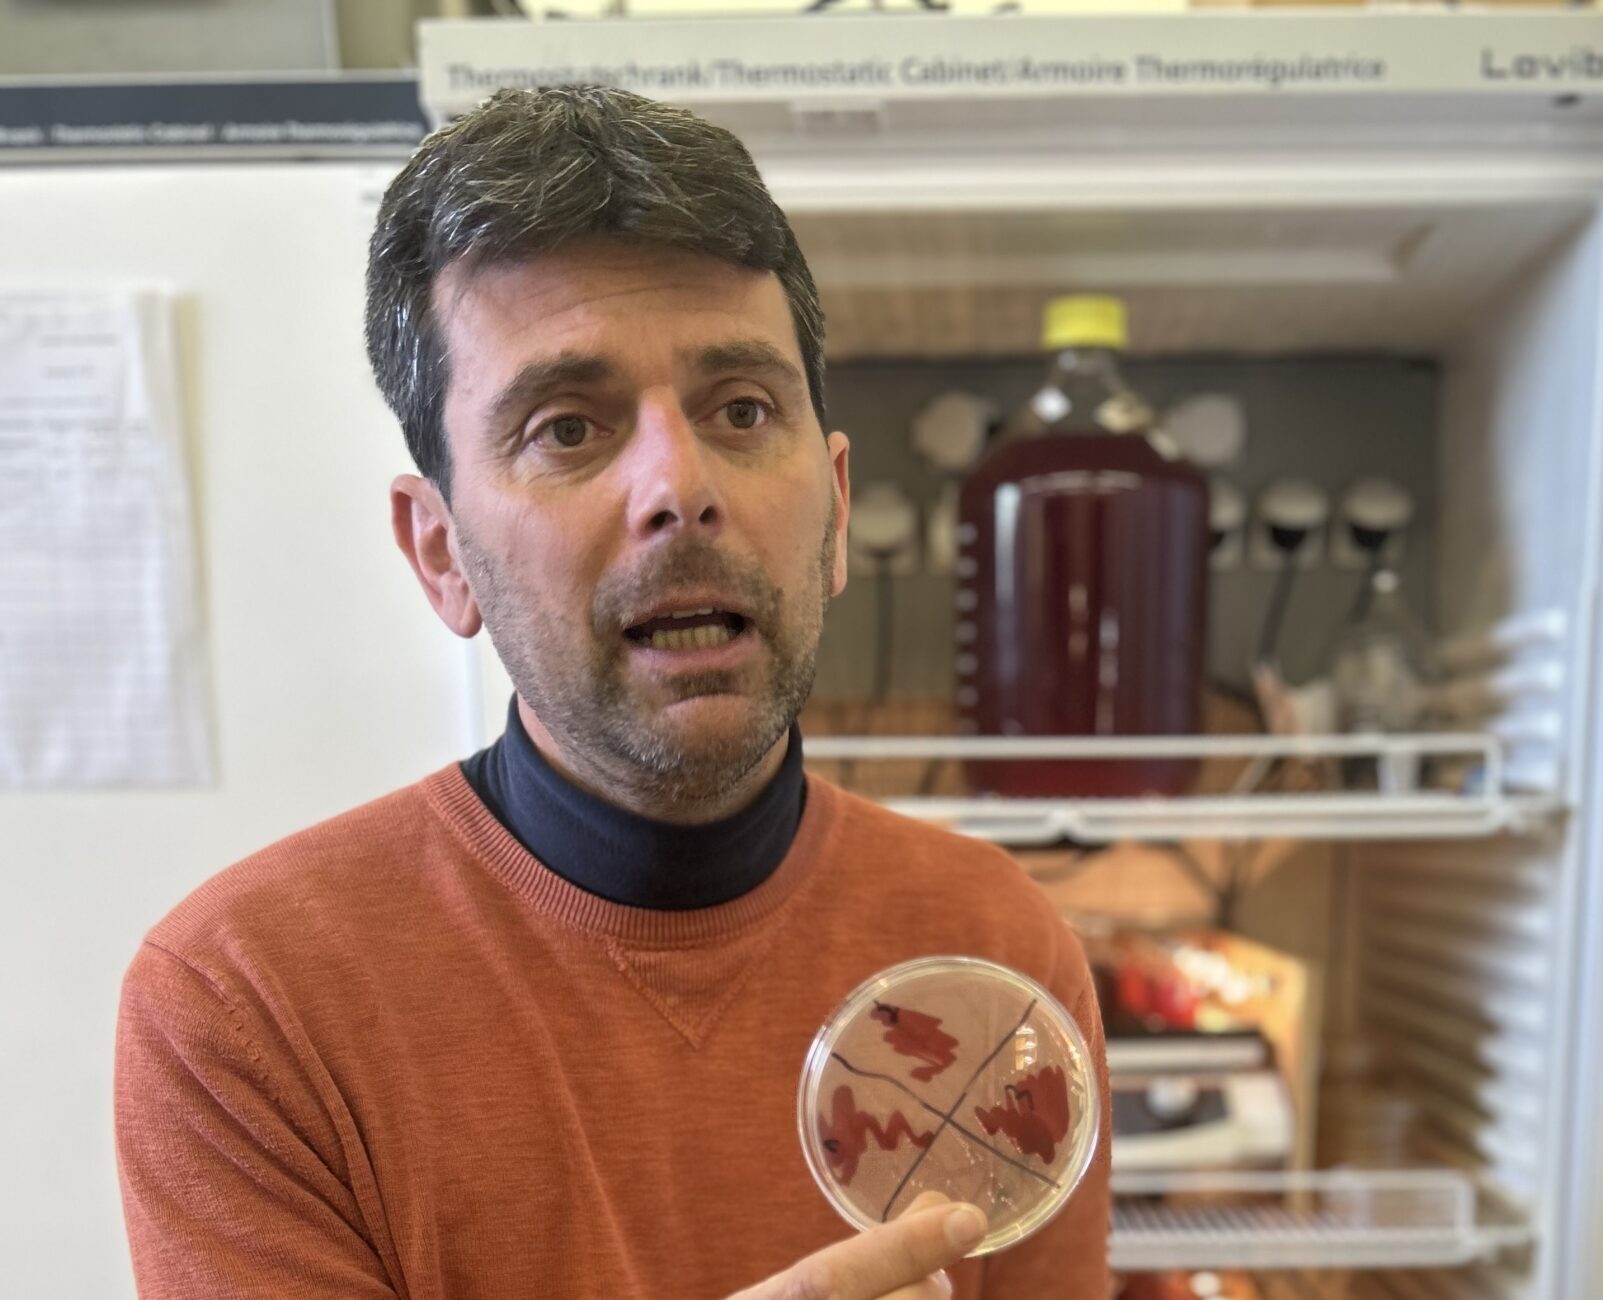

Our story
PurpleTech was founded to translate academic discovery into meaningful nutritional innovation. The company originated from research on photosynthetic microorganisms at University of Mons (UMONS), where scientists explored the unique metabolic capabilities of purple bacteria and their potential as sustainable bio-ingredients.
Established as a university spin-off, PurpleTech bridges fundamental science and real-world application. We develop controlled cultivation processes that ensure consistency, traceability, and responsible production, enabling purple bacteria to become a reliable component of next-generation nutritional supplements.


Today, our work continues to build on strong scientific foundations while advancing a broader vision: harnessing biotechnology to support human health through sustainable innovation.